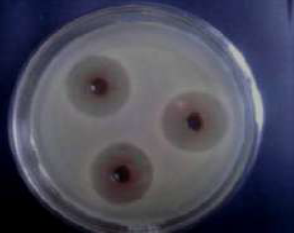

International Journal of
eISSN: 2573-2889


Research Article Volume 4 Issue 2
Department of Applied Microbiology and Brewing, Nnamdi Azikiwe University Awka, Nigeria
Correspondence: Effiong Edet Bassey, Department of Applied Microbiology and Brewing, Nnamdi Azikiwe University Awka, Anambra State, Nigeria
Received: May 10, 2017 | Published: March 19, 2019
Citation: Bassey EE, Ifeayinwa O, Onuorah C, et al. Photochemical screening and in vitro antimicrobial analysis of chloroform, methanol and acetone extracts of leaves of Andrographis paniculata. Int J Mol Biol Open Access. 2019;4(2):38?44. DOI: 10.15406/ijmboa.2019.04.00096
Herbs have been used for centuries to improve health and wellbeing of mankind. Mainstream modern science is now beginning to re-focus on herbs and natural plant therapies as a primary means to deal with current day health issues. Plants have been an essential part of human society since the cultivation. The aim of this study focus on the phytochemicals and in vitro analysis of the antimicrobials activities of chloroform, methanol and acetone extracts of Andrographis paniculata leaves. Phytochemical analysis revealed the presence of flavonoids, alkaloids, glycosides, steroids, phenols, tannins and saponins. In vitro antimicrobial effect of these extracts were tested on four clinical and health important microbes (Staphylococcus aureus, Escherichia coli, Aspergillus niger and Candida albicans) at 400, 200, 100, 50 and 25mg/ml concentrations. The agar well diffusion and serial doubling dilution techniques were employed in this analysis, with azithromycin and fluconazole as the positive controls, whereas drug free and extract free solutions of chloroform, methanol and acetone were used as negative controls. All the extracts showed inhibitory effect on all the test organisms when compared with the positive and negative controls. The inhibitory zone diameter ranges from 50 to 200mg/ml whereas the lethal concentrations ranged from 100 to 200mg/ml. The chloroform extract of this plant was more effective than methanol and acetone extracts, and Staphylococcus aureus proved more sensitive to the extracts than E. coli, Aspergillus niger and Candida albicans; nevertheless the plant extracts were considerably effective against all the organisms tested in this study. Therefore, this study justifies the use of Andrographis paniculata as potential source of antibiotics, and recommends the use of highly effective organic solvents for its extraction.
Keywords: antimicrobial activity, andrographis paniculata, phytochemical screeningminimum inhibitory concentration
Plants have been recognized for their several lifesaving and therapeutic properties. Nearly 70% of the world’s population (mainly in the developing countries) relied mostly on traditional medicine therapies as their basic way of health care.1 Andrographis paniculata Nees (Acanthaceae) known as “king of bitters” is used traditionally as a remedy for fever. The aerial parts of the plant are commonly used to treat cold, hypertension, diabetes, cancer, malaria and snake bite.2 Andrographolides3 are active components found in the aerial part of this plant. Akowuah et al.,4 successfully identified and quantified two major bioactive compounds in A. paniculata, namely andrographolide and 14-deoxy-11, 12-didehydroandrographolide. Andrographolide and 14-deoxy-11, 12-didehydroandrographolide have been characterized as bitter and colourless crystalline diterpene lactone, and as colourless needles, respectively. The herb Andrographis paniculata is found growing in the forests. Medicinal plants have also been found to play an important role in the development of agro-materials to improve crop production.5,6 Moreover, the frequent use of synthetic and commercial antimicrobial drugs in treatments has led to drug resistance in animal, human and plant pathogens.7 The frequent use of synthetic preservative agents and antibiotics such as chloramphenicol in meat products has be of human health concerns. Lipid peroxidation in food lowers the nutritive value of food and causes the flavor and taste of food to deteriorate. Besides that, it raises health issues as it contributes to aging, heart disease, stroke, emphysema, mutagenesis and carcinogenesis.8 Medicinal plants showing antimicrobial and antioxidant activities may have the potential to act as safer substitutes because their molecular structures are different from those of microbes and chemical-based pharmaceuticals; therefore, their mode of action is likely to be different.8 Moreover, it is necessary to suppress lipid peroxidation to ensure that the food is safe for consumption and its flavor enhanced. The beneficial effects of plant materials typically result from the combinations of phyto chemicals that have several biological effects on microorganisms. These phyto chemicals differ from plant to plantand examples include: Anthraquinones, flavonoids, alkaloids, steroids, tannins,9 saponins, glycosides, and terpenoids. The presence of such a phytochemical of interest may lead to its further isolation, purification and characterization.10 Then it can be used as the basis for a new pharmaceutical product. The study is aimed at phyto chemical screening and in vitro microbial analysis of Andrographis paniculata leaves
Equipment
Materials for the study were of analytical grade ad were obtained from microbiology general laboratory, Nnamdi Azikiwe University, Awka.
Collection of plant samples
Andrographis paniculata leaves and stem were collected at Esther Obiakor, phase 3 plantation in Awka, Anambra state, Nigeria. It was collected on 10th April, 2015.
Plant identification
The plant specimen was identified and confirmed by Okeke sam. Okey of the Department of Botany, Nnamdi Azikiwe University, Awka as Andrographis paniculata ,with referece to herbarium sheets(voucher umber 111), available at the herbarium of botany department.
Sample preparation
The leaves of Andrographis paniculata were dried under shade at 25°C for 12 days. The dried leaves were then grinded using an electric blender, and the powdered form was transferred into a clean, stoppered, labeled 250ml conical flask, and kept at room temperature for further use.
Preparation of plant extract
The powdered leaves (50g) was weighed out and wrapped carefully in a filter paper (24cm), and closed firmly at both ends. This was then packed into a soxohlet apparatus and extracted exhaustively with 500ml of acetone, methanol and chloroform respectively. The extract was filtered through what man No. 1 filter paper. The obtained filtrate was evaporated to dryness at 37°C, covered tightly and preserved in the refrigerator at 4°C for further use.
Source of test microorganism
The pure culture of the test organisms (Staphylococcus aureus, Escherichia coli, Candida albicans and Aspergillus niger) were collected from microbiology laboratory Nnamdi Azikiwe University, Awka and sub cultured on a properly prepared Nutrient agar plate and incubated for 24h at 37°C to check for its purity while the fungi Aspergillus niger and Candida albicans were sub cultured in Sabouraud Dextrose Agar (SDA), at 27°C for 48h and 37°C respectively. After 24hours of incubation, pure isolates were stored on agar slant for further use.
Methods
Qualitative analysis of the plant: Chemical tests were carried out on the various extracts using standard procedures to identify the constituents as described by Harborne,11,12 sofowora,13 and Senthil kumar.14 The leaf extracts were screened for alkaloids, flavonoids, steroids, phenols, Saponins, tannins, terpenoids and glycosides.
Test for tannins: To about 1ml of each extract, 2ml of 5% ferric chloride was added and observed for Brownish green or a blue-black colouration.
Test for saponins: To 1ml of each extract, 5-10ml of distilled was added and shaken in a graduated cylinder for 15minutes. Formation of 1cm layer of foam indicates the presence of Saponins.
Test for flavonoids: Three methods were used to determine the presence of flavonoids in the plant sample.11–13 5ml of diluted ammonia solution were added to a portion of the aqueous filtrate of each plant extract followed by addition of concentrated H2SO4. A yellow colouration observed in each extract indicates the presence of flavonoids. The yellow colouration disappeared on standing. Few drops of 1% aluminium solution were added to a portion of each filtrate. A yellow colouration was observed indicating the presence of flavonoids. A portion of the powdered plant sample was in each case heated with 10ml of ethyl acetate over a steam bath for 3minutes. The mixture was filtered and 4ml of the filtrate was shaken with 1ml of dilute ammonia solution. A yellow colouration was observed indicating a positive test for flavonoids.
Test for alkaloids: To 2ml of each extract, 2ml of concentrated hydrochloric acid was added to the mixture above, 3drops of Mayer’s reagent was added. Presence of green colour on white precipitate indicates the presence of alkaloids.
Test for glycosides: To 2ml of each extract, 1ml of glacial acetic acid and 5% ferric chloride was added followed by 3drops of concentrated sulphuric acid. Presence of greenish blue colour indicated the presence of glycosides.
Test for steroids: To 1ml of each extract, equal volume of chloroform and 3 drops of concentrated sulphuric acid was added. Formation of brown ring indicates the presence of steroids.
Test for phenols: To 1ml of each extract, 2ml of distilled water followed by 5drops of 10%ferric chloride was added. Formation of blue or green colour indicates the presence of phenols.
Screening for antimicrobial activity: The susceptibilities of the test organisms to the plant extracts were assayed as described by Garba et al.15
Agar diffusion method: Antimicrobial activity was evaluated using the agar well diffusion method on Mueller Hinton Agar (MHA) for bacteria and Sabouraud Dextrose Agar (SDA) for fungi. Both media were prepared according to manufacturers' recommendations, boiled to dissolve and steam sterilized in the autoclave at 121°C for 15 minutes at 15psi. The sterilized media was subsequently allowed to cool to 45°C and poured aseptically into appropriate number of labelled sterile Petri dishes and allowed to solidity. Prior to analysis, the test organisms from the agar slants were sub-cultured into Sabouraud Dextrose Broth (SDB) for fungi and Nutrient Broth (NB) for bacteria and incubated at 37°C for 18-24hr and at 25°C for 24-48hrs respectively. Each organism was standardized using saline solution (0.85% NaCl) and adjusted to match a turbidity of 0.5 x108 cells/ml using McFarland standard (through visual comparism). 0.lml of the standardized suspensions were used to inoculate the surfaces of Mueller Hinton agar and Sabouraud Dextrose Agar plates (90mm in diameter) accordingly using sterile cotton swab. Three six-millimeter diameter wells were punched into each agar using a sterile cork borer. Two folds dilution of the acetone, methanol and chloroform extract of Andrographis paniculata were made and each hole was filled with the desired concentrations (l00mg/ml, 50mg/ml, and 25mg/ml) of the extracts. Commercial antibiotics (Azithromycin and fluconazole as the positive controls, whereas drug free and extract free solutions of chloroform, methanol and acetone were used as negative controls to determine the sensitivity of the isolates. The plates were allowed to stand for 5 hours at room temperature for the extract to diffuse into the agar and then incubated at 37°C for 18-24h for bacteria and at 25°C for 24-48h for fungi except for the yeast (Candida species) which was incubated at 37°C. After incubation, the zones of inhibition were measured with a meter rule. The entire test was conducted in triplicate and the mean values of zone of inhibition calculated.
Determination of minimum inhibitory concentration (MIC): MIC was determined for only the extracts and on the isolates for which it showed inhibitory activity. Broth dilution technique was employed to determine the MIC of the potent extracts. Doubling dilution of the potent extracts was prepared using mueller Hinton broth (prepared) to obtain a series of dilution containing 200, 100, 50, 25mg/ml of extracts. Standardized inoculums of the test organisms (exactly 0.02ml, equivalent to 20,000 cells) compared with the MacFarland turbidity standard was inoculated into each of the four (4) test-tubes containing 2ml of the mixture. Tubes containing extract-free broth were used as control, and all were incubated at 37°C for 24hours. MIC was read as the least concentration that showed no growth, using turbidity as a measure.
Determination of minimum lethal concentration (MLC): The MBC was determined by collecting 0.2ml of broth culture from the tubes used for the MIC determination (starting from the MIC point backwards) and sub culturing onto fresh extract-free and drug-free solid agar plates. The plates were incubated at 37°C for 24hours. The least concentration that didn’t show any growth after 24h of incubation or the lowest concentration of the extracts that killed 99.9% of the bacterial inoculum was taken as the minimal bactericidal concentration was regarded as the MBC.
Determination of minimal fungicidal concentration (MFC): The Minimal Fungicidal Concentration was determined by sub culturing the test dilutions with no visible growth on Sabouraud Dextrose Agar and further incubated for 48h. The lowest concentration that killed 99.9% of the fungal inoculum was taken as the minimal fungicidal concentration.
Preparation of stock solutions of extract: The stock solutions of the extracts were prepared by dissolving 0.8g of each extract in 2ml of dimethyl sulfoxide (DMSO) to give a concentration of 400mg/ml. This was allowed on the bench overnight to dissolve completely.
Quantitative determinations of leaf extract of Andrographis paniculata
The plant extracts was determined quantitatively using the following methods below.
Estimation of tannins
Estimation of Tannins was carried out using Folin-Denis reagent as reported by AOAC (1980) with some modifications. To 0.20g of the sample 20ml of 50% methanol was added. This was shaken thoroughly and placed in a water bath at 80°C for 1h to ensure uniform mixing. The extract was filtered into a 100ml volumetric flask, followed by the addition of 20ml of distilled water, 2.5ml of Folin-Denis reagent and 10ml of 17% aq.Na2CO3 and was thoroughly mixed. The mixture was made up to 100ml with distilled water; it was then mixed and allowed to stand for 20min. The bluish-green color developed at the end of the reaction mixture of different concentrations ranges from 0 to 10ppm. The absorbance of the tannic acid standard solutions as well as sample was measured after color development at 760nm using the AJI-C03 UV-VIS spectrophotometer. Results were expressed as mg/g of tannic acid equivalent using calibration.
Alkaloid was estimated using Harborne (1973) method
Five (5g) of the sample was weighed into 250ml beaker and 200ml of 10% acetic acid in ethanol was added and covered, the mixture was allowed to stand for 4hour. It was then filtered and the extract was concentrated on a water bath to one quarter of the original volume. Concentrated ammonium hydroxide was then added in a drop-wise manner to the extract until precipitation was complete. The whole solution was allowed to settle and the precipitate was collected and was washed with 0.1% dilute ammonium hydroxide and was then filtered. The residue was the alkaloid, which was then dried and weighed.
Flavonoids determined using the method of Bohm & Koapai-Abyazan (1994)
10g of the plants sample was extracted repeatedly with 100ml of 80% aqueous methanol at room temperature. The whole solution was filtered through What man’s filter paper NO.42(125mm). The filtrate was then transferred into crucible and evaporated into dryness over a water bath and weighed to a constant weight.
Saponins determination
Quantitative determination of Saponins was done using the method of Obadoni.16The powdered sample (20g) was added to 100 ml of 20% aqueous ethanol and kept in a shaker for 30min. The samples were heated over a water bath for 4 h at 55°C. The mixture was then filtered and the residue re-extracted with another 200ml of 20% aqueous ethanol. The combined extracts were reduced to approximately 40ml over the water bath at 90°C. The concentrate was transferred into a 250ml separatory funnel and extracted twice with 20ml diethyl ether. The ether layer was discarded while the aqueous layer was retained and to which 60 ml n-butanol was added. The n-butanol extracts were washed twice with 10ml of 5% aqueous sodium chloride. The remaining solution was heated on a water bath. After evaporation, the samples were dried in the oven at 40°C to a constant weight. The Saponins content was calculated using the formula: % Saponins=final weight of sample/initial weight of extracts x 100.
Determination of total phenols by spectrophotometer
The fat free sample was boiled with 50ml of ether for the extraction of the phenolic component for 15minutes. 5ml of the extract was taken into a 50ml flask, and then 10ml of distilled water was added. 2ml of ammonium hydroxide solution and 5ml of concentrate amyl alcohol was also added. The samples were made up to mark and left to react for 30minutes for colour development.17 It was then measured at 505nm. These data was used to estimate the total phenolic content using a standard calibration curve that was obtained from various diluted concentrations of gallic acid.
Glycosides determination
5g of the sample was soaked in distilled water for 3 hours 1ml of the extract was measured into a test tube, and 2mls of DNS reagent added. The test tube is placed in a beaker of boiling water and boiled for 5 minutes, cooled in cold water, and10mls of distilled water added. The absorbance was read at 540nm using spectronic 20: The Glycoside content was calculated using the formula: % Glycoside = conc x vol of extract x100/1000 x weight of sample.
Preliminary phytochemical screening
Preliminary phyto chemical screening of chloroform, methanol and acetone extracts is presented in Table 1. The results showed that Glycosides phenols and steroids are present in the three extracts. Saponins are present in chloroform and methanol extracts, tannins are present in methanol and acetone extracts while alkaloid and flavonoids were absent in methanol and acetone extracts respectively, but present in chloroform extracts.
Phyto constituents |
Methanol extract |
Acetone extract |
Chloroform extract |
|
L |
L |
L |
Alkaloids |
- |
- |
+ |
Flavonoids |
- |
- |
+ |
Saponins |
+ |
- |
+ |
Glycosides |
++ |
+ |
+ |
Phenol |
++ |
++ |
+ |
Tannins |
+ |
+ |
- |
Steroids |
++ |
+ |
+ |
Table 1 Experimental results on qualitative analysis of andrographis paniculata
L, Leaves, -absent, +present, ++moderate, +++maximum
Quantitative phytochemical screening
Quantitative determinations of phyto constituents such as alkaloids, flavonoids, saponins,tannins and phenols were carried out and the result presented in Table 2. The results showed that chloroform extract of A. paniculata exhibited higher yield in flavonoids (19.51) and alkaloids (6.73) compared to methanol and acetone extracts both of which exhibited higher yields of Glycosides, (8.32, 6.12), Phenol, (7.95, 8.40), tannins, (6.64, 6.21) and Steroids, (2.57 0.81). Saponins however was found only in methanol and chloroform extracts (4.09, 3.01).
Phytoconstituents |
Methanol |
Acetone |
Chloroform |
Alkaloids |
0 |
0 |
6.73 |
Flavonoids |
0 |
0 |
19.51 |
Glycosides |
8.32 |
6.12 |
3.19 |
Phenol |
7.95 |
8.4 |
0.71 |
Saponins |
4.09 |
0 |
3.01 |
Tannins |
6.64 |
6.21 |
0 |
Steroids |
2.57 |
0.81 |
0.23 |
Table 2 Experimental results on quantitative analysis of andrographis paniculata leaf extracts using methanol, acetone and chloroform in percentage %
Antimicrobial activity
Results of the antimicrobial activity screening of methanol extracts of leaf of Andrographis paniculata revealed significant antimicrobial activity against all tested microbial strains. The results are shown in Table 3. The chloroform extract of leaf of Andrographis paniculata showed more significant activity against all tested microbial organisms, followed bymethanol extract and then acetone extract. The maximum antimicrobial activity of chloroform extracts of Andrographis paniculata was exhibited against Staphylococcus aureus. The effects of Andrographis paniculata18 leaf on the test micro-organisms may be due to the presence of the above phytochemical components. The various phyto chemical constituents found are known to be beneficial in medicinal science. Antibacterial activities of the extracts could be attributed to the presence of several types of compounds belonging to different classes, such as flavonoids19 and the more polar thermo-labile and thermo-stable phenolics.20 The flavonoids have been the nature’s biological response modifiers, because of their ability to modify the body’s reaction to allergies and viruses. They also have anti-allergic, anti-inflammatory,21 antioxidant, anti-microbial and anti-cancer activities.22 The phenols along with antimicrobial activity also show astringent properties.23 Alkaloids generally present play some metabolic role and control development in living system.24 They have been used in the treatment of diseases like malaria. They also have protective function and are used as medicine especially the steroidal alkaloids.25 Generally, glycosides are non volatile and lack fragrance but cleaving the glycosidic bond yields the aglycone, which appears volatile and fragrant. Glycosides serve as defense mechanisms against many micro-organisms.26 It is also known that steroidal compounds are of importance and interest in pharmacy due to their relationship with sex compounds Okwu DE.27 Plant steroids are known to be important for their cardiotonic and insecticidal activities. Tannins at low concentration can inhibit the growth of microorganisms and act as an antifungal agent at higher concentration by coagulation effect on the protoplasm of microorganism.28 Saponins protect against hypercholesterolemia and has antibiotic properties, thus protects against microbes and fungi. It is also in the management of inflammations. It is also used to allow antibody access in intracellular proteins. In medicine, it is used for hyperglycaemia, antioxidant, anticancer, weight loss.29 The extracts of Andrographis paniculata30,31 leaf showed zones of Inhibition, ranging from 15-30mm, excluding that of controls (Figure 1 & Figure 2). The Results revealed that chloroform extracts was significantly active against Staphylococcus aureus followed by Escherichia coli, Aspergillus niger and Candida albicans in that order. Also methanol extracts were more effective against Staphylococcus aureus followed by Escherichia coli, Aspergillus niger and Candida albicans in that order. The same trend was observed in the acetone extracts. On the whole, chloroform extracts gave a higher antimicrobial activity than methanol32 and acetone extracts respectively. The result of the Minimum Inhibitory Concentration (MIC) Figure 3 assay is shown in Table 4 Chloroform extracts exhibited the highest inhibition against Staphylococcus aureus and Escherichia coli at 50mg/ml but 100mg/ml against Aspergillus niger and Candida albicans. Also methanol extracts showed inhibition against Staphylococcus aureus and Escherichia coli at 100mg/ml but 200mg/ml against Aspergillus niger and Candida albicans. While acetone extracts inhibited Staphylococcus aureus and Escherichia coli at 100mg/ml but showed no effect against Aspergillus niger and Candida albicans. The Minimum Lethal Concentration (MLC) Figure 4 of the extracts is shown in Table 5. Generally the Chloroform extracts exhibited the highest lethal effect against Staphylococcus aureus at 100mg/ml and Escherichia coli at 200mg/ml but 200mg/ml against Aspergillus niger and Candida albicans respectively, followed by methanol extracts which showed its lethal effect against all the organisms at 200mg/ml concentrations.33,34 However the acetone extracts showed its lethal effect against Staphylococcus aureus at 200mg/ml but has no effect against Escherichia coli, Aspergillus niger and Candida albicans respectively Figure 5.
Test organisms |
Concentration (mg/ml) |
Inhibition zone diameter (mm) |
||
Chloroform |
Methanol |
Acetone |
||
Escherichia coli |
400 |
25.4 |
24.6 |
24.3 |
25(RSD*) |
25.3 |
25.3 |
25.3 |
|
Staphylococcus aureus |
400 |
30 |
26.5 |
25.8 |
25(RSD*) |
31.1 |
31.1 |
31.1 |
|
Aspergillus niger |
400 |
22.5 |
20.3 |
17.2 |
25(RSD*2) |
23.4 |
23.4 |
23.4 |
|
Candida albicans |
400 |
20.3 |
15.4 |
16.2 |
|
25(RSD*2) |
23.5 |
23.5 |
23.5 |
Table 3 Preliminary screening of antimicrobial activity of methanol, acetone and chloroform extracts of andrographis paniculata leaf
RSD*, Reference standard drug 25mg/ml (Azithromycin), RSD*2, reference standard drug 25mg/ml (Fluconazole).
Test organisms |
Extract |
Concentration (mg/ml) |
MIC |
|||
|
|
200 |
100 |
50 |
25 |
|
Escherichia coli |
Chloroform |
- |
- |
- |
+ |
50 |
Methanol |
- |
- |
+ |
+ |
100 |
|
Acetone |
- |
- |
++ |
++ |
100 |
|
Staphylococcus aureus |
Chloroform |
- |
- |
- |
+ |
50 |
Methanol |
- |
- |
+ |
++ |
100 |
|
Acetone |
- |
- |
+ |
++ |
100 |
|
Aspergillus niger |
Chloroform |
- |
- |
+ |
+ |
100 |
Methanol |
- |
+ |
++ |
++ |
200 |
|
Acetone |
+ |
+ |
++ |
++ |
- |
|
Candida albicans |
Chloroform |
- |
- |
+ |
+ |
100 |
Methanol |
- |
+ |
++ |
++ |
200 |
|
|
Acetone |
+ |
++ |
++ |
++ |
- |
Table 4 Minimum inhibitory concentration (MIC) based on microbial turbidity
+, Microbial growth, ++, Profuse microbial growth, -, No microbial growth
Test Organisms |
Extract |
Concentration (mg/ml) |
|
MLC |
||
|
|
200 |
100 |
50 |
25 |
|
Escherichia coli |
Chloroform |
- |
+ |
+ |
++ |
200 |
Methanol |
- |
+ |
++ |
++ |
200 |
|
Acetone |
++ |
+ |
++ |
++ |
- |
|
Staphylococcus aureus |
Chloroform |
- |
- |
+ |
++ |
100 |
Methanol |
- |
+ |
+ |
++ |
200 |
|
Acetone |
- |
+ |
++ |
++ |
200 |
|
Aspergillus niger |
Chloroform |
- |
+ |
++ |
++ |
200 |
Methanol |
+ |
++ |
++ |
++ |
200 |
|
Acetone |
+ |
++ |
++ |
++ |
- |
|
Candida albicans |
Chloroform |
- |
+ |
++ |
++ |
200 |
Methanol |
- |
+ |
++ |
++ |
200 |
|
|
Acetone |
+ |
+ |
++ |
++ |
- |
Table 5 Minimum lethal concentration (MLC) based on microbial growth
+ Microbial growth, ++ Profuse microbial growth, - No microbial growth

Figure 1 Preliminary Screening of antibacterial activity of extracts of methanol, acetone and chloroform on escherichia coli.
Figure 2 Preliminary screening of antibacterial activity of extracts of methanol, acetone and chloroform on staphylococcus aureus.
According to the results obtained in this study, one is poised to arrive at the conclusion that Andrographis paniculata is a strong natural antimicrobial plant, with broad spectrum potential for treatment of both bacterial and fungal infections and other disease conditions. Thus, they can be used in the treatment of infectious diseases caused by resistant microbes. Plant tissues contain secondary metabolites with antibacterial and antifungal activities and thus are sources of natural bioactive molecules to control pathogens that cause disease in humans.
In addition, this research provided more scientific supporting gravels in favor of the users of this plant, both for food preparation and therapeutic purpose to explore more of its potential qualities. There is no doubt that plants have continued to offer a large range of natural compounds, belonging to different molecular families, which have various properties to humans. Obviously, traditional medicinal plants are cheaper than the orthodox medicines which are not only expensive but also not readily available to the rural dwellers. This calls for more research in the use of traditional (natural) medicinal plants and the validation of the use of herbs in various African localities and across the World in order to integrate them into health care system. This also borrow further credence from the present agitation on the use of natural products (such as green vegetables and fruits) over synthetic products (drugs) as tools for improving body immunity and good health. The test organisms were more sensitive to the chloroform extracts than the methanol and acetone, showing that the potential of plant extract is in part dependent on the solvent used.
None.
The author declares there is no conflicts of interest.

©2019 Bassey, et al. This is an open access article distributed under the terms of the, which permits unrestricted use, distribution, and build upon your work non-commercially.